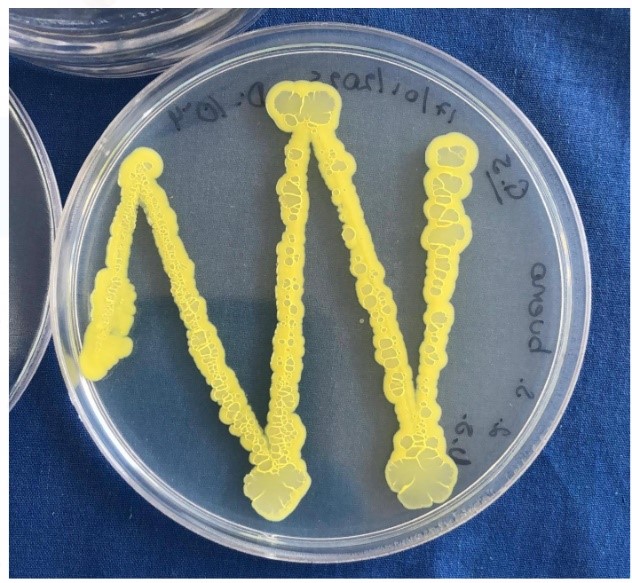
Coleoptera

Estudiar la diversidad y composición de la comunidad microbiana del suelo y de escarabajos estercoleros (Coleoptera: Scarabaeinae) en un gradiente paisajístico en bosques montanos del Sur del Ecuador, para ello se realiza el aislamiento de bacterias del intestino de escarabajos y del suelo de tres áreas de sucesión ecológica de la Reserva El Madrigal del Podocarpus. Así también caracterizar mediante métodos dependientes de cultivo la morfología y características metabólicas de los aislados, y, finalmente la caracterización molecular a partir de secuenciación de ADN de los aislados obtenidos.
Estado
En ejecución
Duración
2022-2025

